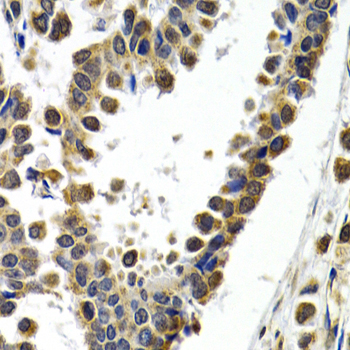
A2155: image 3
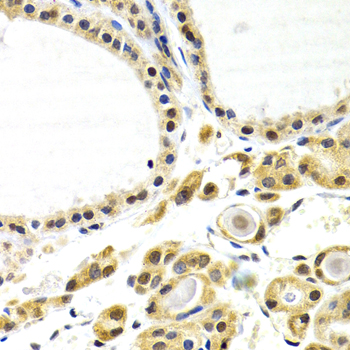
A2155: image 4
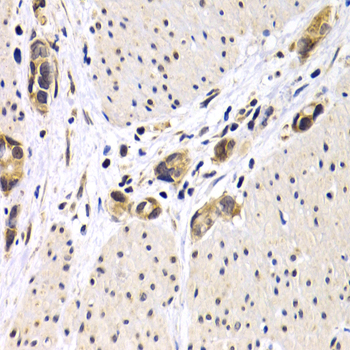
A2155: image 5

For quotations, please use our online quotation form, and you may also contact us by
sales@neoscientific.com
+1-888.733.6849
+1-617.299.7367 (Int’l)
+1-888.733.6849
+1-617.299.7367 (Int’l)
| Reactivity | Human Mouse Rat |
| Tested applications | WB IHC IF |
| Recommended Dilution | WB 1:500 - 1:2000 IHC 1:50 - 1:200 IF 1:50 - 1:200 |
| Calculated MW | 56kDa |
| Observed MW | Refer to Figures |
| Immunogen | Recombinant protein of human ATF2 |
| Storage Buffer | Store at -20℃. Avoid freeze / thaw cycles. Buffer: PBS with 0.02% sodium azide, 50% glycerol, pH7.3. |
| Concentration | fk |
| Synonym | CRE-BP1; CREB2; HB16; MGC111558; TREB7; |

Western blot analysis of extracts of various cells, using ATF2 antibody.

Immunohistochemistry of paraffin-embedded human normal breast using ATF2 antibody at dilution of 1:200 (400x lens).
Immunohistochemistry of paraffin-embedded human breast cancer using ATF2 antibody at dilution of 1:200 (400x lens).
Immunohistochemistry of paraffin-embedded human normal thyroid using ATF2 antibody at dilution of 1:200 (400x lens).
Immunohistochemistry of paraffin-embedded human stomach cancer using ATF2 antibody at dilution of 1:200 (400x lens).

Immunofluorescence analysis of U20S cell using ATF2 antibody. Blue: DAPI for nuclear staining.
The transcription factor ATF-2 (also called CRE-BP1) binds to both AP-1 and CRE DNA response elements and is a member of the ATF/CREB family of leucine zipper proteins (1). ATF-2 interacts with a variety of viral oncoproteins and cellular tumor suppressors and is a target of the SAPK/JNK and p38 MAP kinase signaling pathways (2-4). Various forms of cellular stress, including genotoxic agents, inflammatory cytokines, and UV irradiation, stimulate the transcriptional activity of ATF-2. Cellular stress activates ATF-2 by phosphorylation of Thr69 and Thr71 (2-4). Both SAPK and p38 MAPK have been shown to phosphorylate ATF-2 at these sites in vitro and in cells transfected with ATF-2. Mutations of these sites result in the loss of stress-induced transcription by ATF-2 (2-4). In addition, mutations at these sites reduce the ability of E1A and Rb to stimulate gene expression via ATF-2 (2).
N/A